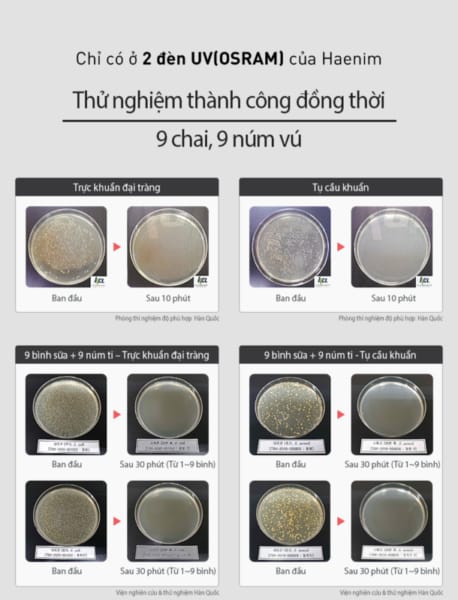

Máy tiệt trùng bình sữa bằng tia UV, Haenim CLASSIC
– 99.99% vi khuẩn được tiệt trùng bằng tia UV.
– 2 đèn UV (OSRAM) | Bảo hành 3 năm.
– Phù hợp với tất cả các loại bình sữa. (BPA-FREE : Silicone, PPSU, PP, PES).
– Chế độ SMART | Chế độ TURBO | Chế độ AUTO | Chức năng cảnh báo CLEAN.

Máy tiệt trùng bình sữa bằng tia UV, Haenim CLASSIC là mẫu thiết kế đồ gia dụng gia đình thông minh với công thức đặc biệt. Tiện lợi, xử lý và bảo vệ các thiết bị tối ưu,máy tiệt trùng bình sữa, làm sạch, chăm sóc sức khỏe gia đình.
Đặc điểm thiết kế của máy tiệt trùng bình sữa bằng tia UV, Haenim CLASSIC
Máy tiệt trùng đa năng Haenim UV là dòng phẩm chăm sóc và bảo vệ da đình thông minh.
Kiểu dáng thanh lịch, đơn giản
- Không thiết kế theo phong cách sang trọng như các sản phẩm khác, Máy tiệt trùng bình sữa bằng tia UV, Haenim CLASSIC sở hữu thiết kế thanh lịch.
- Kiểu dáng máy hình khối chữ nhật chắc chắn nhỏ gọn.
- Đường chỉ thanh mảnh thiết kế mặt trước máy với màu sắc đa dạng.
- Kích thước thiết kế tiêu chuẩn hiện tại đạt: 295(ngang) * 375(sâu) * 428(cao) mm, phù hợp với nhiều vị trí trong gia đình.
- Khoang khử trùng rộng, môi trường đặc biệt phù hợp với nhiều đồ dùng.
Chất liệu cao cấp
- Vỏ máy được bao phủ bởi chất liệu cao cấp, phủ lớp sơn bảo vệ.
- Màu sắc thiết kế máy đa dạng.
- Máy tiệt trùng bình sữa bằng tia UV, Haenim CLASSIC thiết kế 4 chân trụ đứng chắc chắn cho hoạt động hiệu quả.
![[BH 12 Tháng] Máy Tiệt Trùng Đa Năng Haenim UV Thế Hệ 4](http://baby68.com.vn/wp-content/uploads/2020/08/may-tiet-trung-binh-sua-bang-tia-uv-haenim-classic-26570-1.jpg)
Hiệu suất vận hành vượt trội
Máy tiệt trùng bình sữa bằng tia UV, Haenim CLASSIC có nhiều điểm cải tiến hơn so với thiết kế đời trước:
Duy trì tính năng cơ bản của thế hệ 3
- Máy tiệt trùng bình sữa bằng tia UV, Haenim CLASSIC vẫn được duy trì các chế độ: khử trùng, sấy khô và diệt khuẩn.
- Có hỗ trợ thời gian tiêu chuẩn cho mỗi chế độ.
- Vận hành theo cơ chế cũ.
Tính năng vượt trội chỉ có ở máy tiệt trùng bình sữa bằng tia UV, Haenim CLASSIC
- Hỗ trợ làm sạch tối ưu đến 99.95 các loại vi khuẩn. Đặc biệt có tác dụng bảo vệ các đồ dùng cho mẹ và bé.
- Khả năng tiết kiệm điện năng sử dụng lên đến 84%.
- Các chức năng hoạt động có thể rút ngắn thời gian so với thế hệ trước khoảng 10 phút.
- Máy tự cảm nhận và điều chỉnh nhiệt độ phù hợp.
- Chế độ tự động hoạt động thông minh: tự động sấy khô và tự động thông gió.
- Chức năng tự động làm sạch sau 60h sử dụng.
- Hệ thống cửa thông minh không nhìn thấy tia Uv, bảo vệ mắt người nhìn.
![[BH 12 Tháng] Máy Tiệt Trùng Đa Năng Haenim UV Thế Hệ 4](http://baby68.com.vn/wp-content/uploads/2020/08/may-tiet-trung-binh-sua-bang-tia-uv-haenim-classic-26570-2.jpg)
Hướng dẫn sử dụng
Máy tiệt trùng bình sữa bằng tia UV, Haenim CLASSIC sử dụng nguồn điện gia đình 220V, 60Hz.
Công suất hoạt động tương đối ổn định ở mức 70W.
Sau khi kết nối nguồn điện có thể cho đồ dùng đã chuẩn bị vào máy để khử trùng.
Chọn chế độ và thời gian sử dụng phù hợp.
Sau khi hoàn thành có thể lấy đồ dùng ra sử dụng.
Lưu ý:
Chọn thời gian phù hợp với mỗi chức năng và số lượng đồ.
Sử dụng máy theo hướng dẫn của nhà sản xuất.
![[BH 12 Tháng] Máy Tiệt Trùng Đa Năng Haenim UV Thế Hệ 4](http://baby68.com.vn/wp-content/uploads/2020/08/may-tiet-trung-binh-sua-bang-tia-uv-haenim-classic-26570-3.jpg)
Thiết kế máy tinh tế, ấn tượng

MÁY TIỆT TRÙNG UV Haenim CLASSIC – Trợ thủ đắc lực của mẹ đây rồi !
Máy tiệt trùng #Haenim BASIC đã tốt – Máy tiệt trùng #Haenim CLASSIC còn tốt hơn.
Máy tiệt trùng UV Haenim được thiết kế để làm mãn nhãn, thoả lòng các bố và các mẹ trót yêu nét hiện đại, tinh tế nhưng không kém phần sang trọng.
Mẹ không còn phải trải qua nhiều công đoạn khi vệ sinh bình sữa cho bé hay các vật dụng khác,…vì bây giờ 01 chiếc máy của Haenim có thể đảm nhận mọi chức năng đó rồi.

- Chế độ thông minh: ứng dụng tính năng AI tự động phát hiện nhiệt độ bên trong và kích hoạt chức năng Auto. Ngoài ra máy sẽ tự động khử trùng và làm khô trong vòng 01 phút khi cửa được mở và đóng.
- Chế độ Turbo: Khi các mẹ bận rộn và cần đẩy nhanh thời gian tiệt trùng của máy, chế độ Turbo giúp quá trình sấy khô và tiệt trùng diễn ra nhanh hơn với 3 cấp độ ( 20 phút – 40 phút – 60 phút), mà vẫn đảm bảo các bình sữa và phụ kiện đều được tiệt trùng hoàn toàn.
- Chức năng làm sạch: Haenim UV 04 sẽ tính toán mức độ sử dụng và khi đến lúc cần làm sạch, máy sẽ hiển thị cảnh báo trên màn hình. Nếu chức năng làm sạch hoạt động, sau khi làm sạch nhấn nút trong 3 giây để thiết lập lại.








































Đánh giá
Chưa có đánh giá nào.